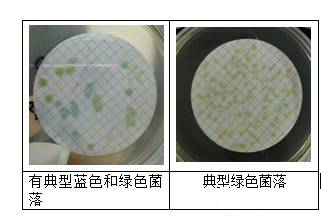
CN板上是蓝绿色疑似铜绿假单胞菌的菌落

饮用水中铜绿假单胞菌的污染、控制及检验
发布时间:2025-05-08 浏览次数:6627 分享:
我们经常看见这样的报道,某某饮用水厂商的一批饮用水中被查出铜绿假单胞菌超标,饮用水呈绿色,网友们纷纷调侃,水都不能喝了,该怎么生存?那么铜绿假单胞菌到底是什么?它是如何进入到饮用水中的?我们该如何预防这种细菌的侵害?

铜绿假单胞菌( P.Aeruginosa )
一种重要的水源性致病菌,广泛存在于各类型水中,对消毒剂、干燥、紫外线等理化因素及不良环境具有很强的抵抗力;作为条件致病菌,可能引起急性肠道炎、脑膜炎、败血症和皮肤炎症等疾病。因此,监测分析其污染原因并进行有效控制显得尤为重要。
1 铜绿假单胞菌如何进入饮用水中的?

瓶(桶)装水中铜绿假单胞菌的污染主要原因有水源受到污染,或现有的较为简单的水生产加工工艺;或生产过程中卫生控制不严格,从业人员未经消毒的手直接与矿泉水或容器内壁接触;或包装材料未进行彻底清洗消毒。
2 检验

检查食品(饮用水)中的铜绿假单胞菌成为食品抽检必不可少的检测项目,以检测饮用水为例列举铜绿假单胞菌的检测方法(GB 8538-2016 食品安全国家标准 饮用天然矿泉水检验方法):
一、检验流程:

二、操作步骤:
1,水样过滤
在100级的洁净工作台进行过滤操作。首先用无菌镊子夹取灭菌滤膜边缘部分,将粗糙面向上,贴放在已灭菌的滤床上,固定好滤器,将250mL水样或稀释液通过孔径0.45μm的滤膜过滤,然后将过滤后的滤膜贴在已制备好的CN琼脂平板上,平铺并避免在滤膜和培养基之间夹留着气泡。
2,培养
将平板倒置于36℃士1 C培养24 h~48 h,并防止干燥。
3,结果观察
在培养20 h~24 h和40 h~48 h后观察滤膜上菌落的生长情况并计数。
计数所有显蓝色或绿色(绿脓色素)疑似铜绿假单胞菌的菌落,并进行绿脓菌素确证性试验。
在紫外线下检查滤膜时,应避免长时间在紫外光下照射,否则可能会将平板上的菌落杀灭,而导致无法在证实培养基上生长。计数滤膜上所有发荧光不产绿脓色素疑似铜绿假单胞菌菌落,并进行乙酰胺肉汤确证性试验。
将其他所有红褐色不发荧光的菌落进行氧化酶测试、乙酰胺液体培养基、金氏B培养基确证性试验,培养20 h~24 h观察结果,防止因为培养40 h~48 h导致菌落过分生长而出现菌落融合。
在CN琼脂上生长的菌落选择和验证步骤见表31。

三、生化鉴定
1、若CN板上是蓝绿色(如下图)疑似铜绿假单胞菌的菌落,需进行绿脓菌素确证性试验
绿脓菌素试验:取可疑菌落2个~3个,分别接种在绿脓菌素测定培养基上,置36℃±1℃培养24h±2h,加入三氯甲烷3mL~5mL,充分振荡使培养物中的绿脓菌素溶解于三氯甲烷液内,待三氯甲烷提取液呈蓝色时,用吸管将三氯甲烷移到另一试管中并加入1mol/L的盐酸1mL左右,振荡后,静置片刻。如上层盐酸液内出现粉红色到紫红色时为阳性,表示被检物中有绿脓菌素存在。
1.1绿脓菌素测定培养基中加入三氯甲烷后的颜色(如下图)

1.2用吸管将三氯甲烷移到另一试管内加入盐酸,振荡,静置(如下图)

1.3蓝色菌落呈粉红色,绿色菌落呈淡粉色,有绿脓菌素存在。
2、若CN板上有荧光(如下图)
按照GB85538-2016标准,产荧光(非蓝绿)要进行产氨实验。

2.1将产荧光的菌落的纯培养物接种到乙酰胺肉汤中36℃培养24h,加入钠氏试剂(如下图)。

3、若CN板上是红褐色
按照GB85538-2016标准,红褐色菌落要进行产氨试验、氧化酶试验。金氏B产荧光试验。
鉴于本人经验有限,接触样品不多,买的标准菌株也是绿色形态(前面那株蓝色菌落也是样品中发现的,甚是宝贵)。所以,至今未见过红褐色菌落,若有同行有检出或者见过,还望交流,多加学习。
3.1标准菌株形态(如下图)

3.2产氨实验(同上,略)
3.3氧化酶试验(如下图)

3.4金氏B产荧光试验(如下图)

4、其他
其他非前面三种,则判断不是铜绿假单胞菌。
来源:食品论坛网友原创分享、国标等,食品微生物检测小编编辑整理,图片来源网络、图怪兽等,转载请注明来源。






